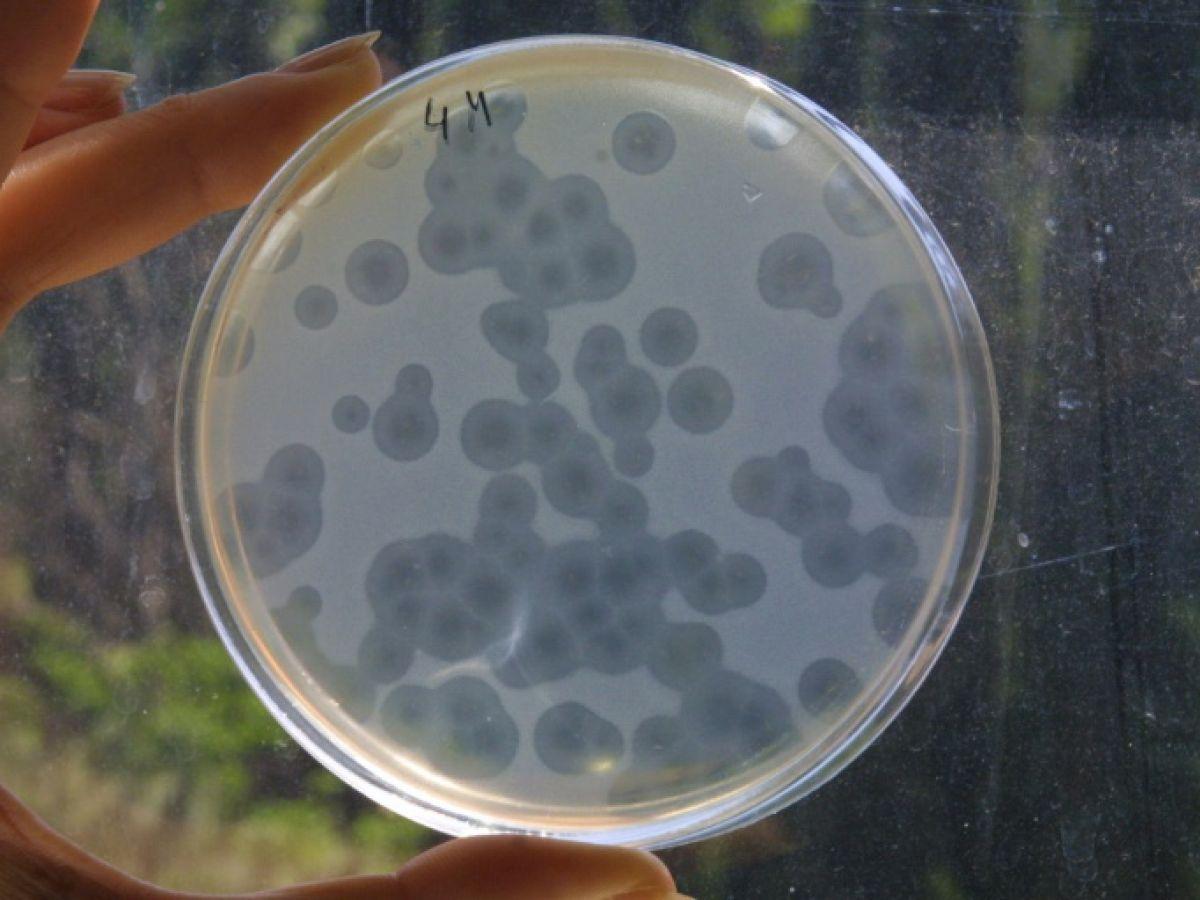
Les infections bactériennes, deuxième cause de décès dans le monde Les infections bactériennes, deuxième cause de décès dans le monde

Africa-Press – Benin. Les infections d’origine bactérienne sont la deuxième cause de décès dans le monde, après les troubles cardiaques, montre une très vaste étude publiée mardi 22 novembre, citant le staphylocoque doré et le pneumocoque parmi les bactéries les plus meurtrières.
Un décès sur huit causé par une bactérie
Cette étude, publiée dans le Lancet, a sélectionné une trentaine de bactéries – les plus couramment impliquées dans des infections – et évalué combien de décès leur étaient associés. Ces mesures sont effectuées dans le cadre du Global Burden of Disease (qu’on peut traduire par « Poids mondial de la maladie »). Ce vaste programme de recherche, financé par la fondation Bill Gates, est d’une ampleur sans équivalent, impliquant plusieurs milliers de chercheurs dans la majeure partie des pays du monde.
Au final, « les morts associés à ces bactéries constituent la deuxième cause de décès à travers le monde » après les maladies coronariennes, qui comprennent notamment les infarctus, concluent les auteurs. Avec 7,7 millions de morts liés à une infection bactérienne, un décès sur huit peut leur être attribué, même si ces chiffres remontent à 2019, avant la pandémie de Covid.
Le staphylocoque doré, en tête dans 135 pays
Sur la trentaine de bactéries retenues, cinq concentrent à elles seules plus de la moitié des décès : le staphylocoque doré, E. coli, le pneumocoque, Klebsellia pneumoniae et le bacille pyocyanique. Le staphylocoque doré est « la principale cause bactérienne de décès dans 135 pays », précise l’étude. Chez les plus petits – moins de cinq ans -, ce sont toutefois les infections à pneumocoque qui se révèlent les plus meurtrières.
Pour les chercheurs, ces résultats illustrent combien les infections bactériennes sont une « priorité urgente » en matière de santé publique. Ils appellent à travailler sur la prévention des infections, un meilleur usage des antibiotiques – pour éviter notamment les phénomènes de résistance -, et un usage plus efficace de la vaccination.
Pour plus d’informations et d’analyses sur la Benin, suivez Africa-Press